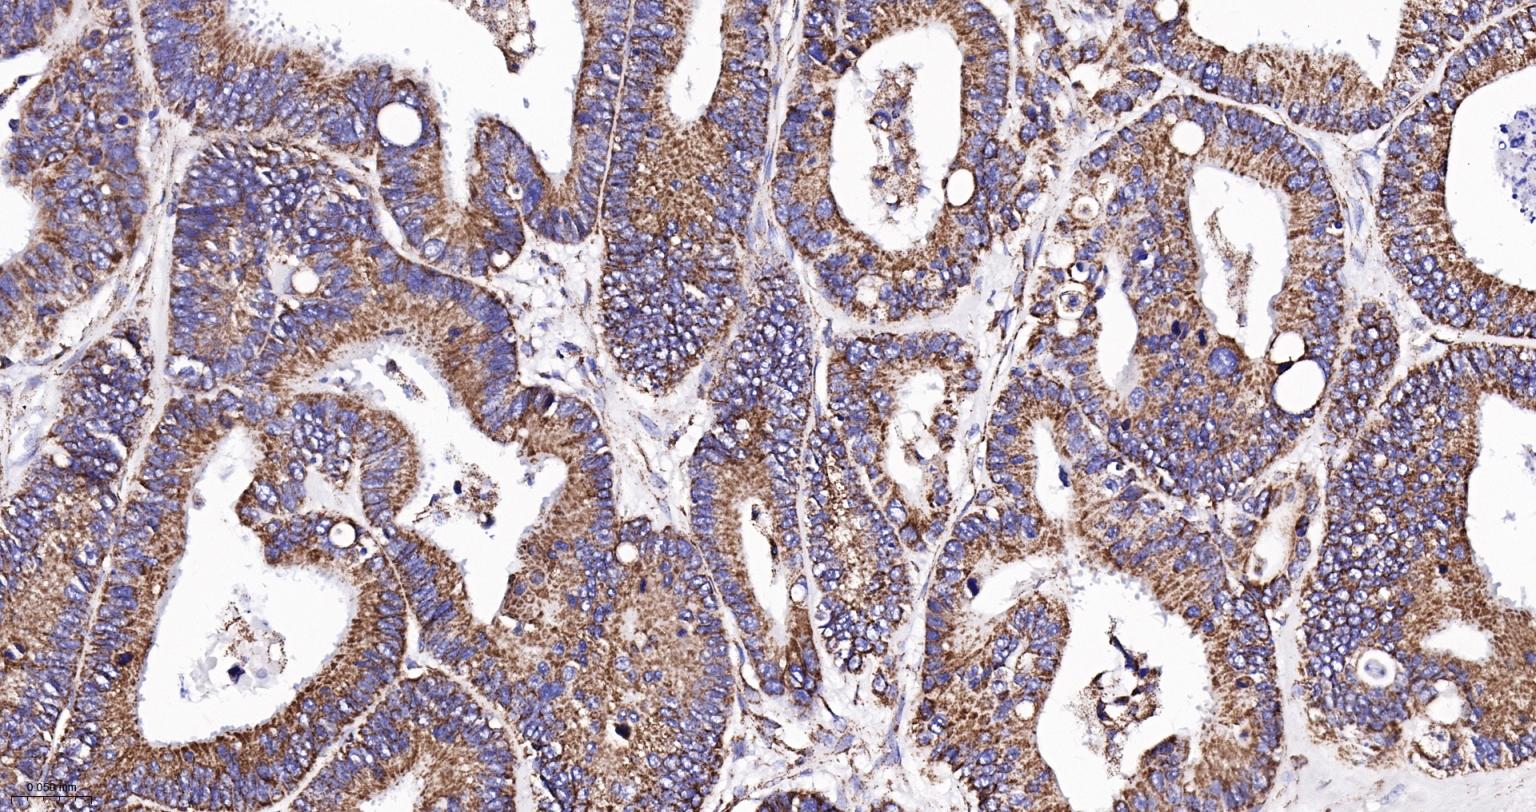
ATP5A重组兔单抗-bsm-61444R

ATP5A Recombinant Rabbit mAb (一抗) - WB,IHC-P,IHC-F,IF,Flow-Cyt,ICC/IF | Bioss

概述
Metabolism > Pathways and Processes > Mitochondrial Metabolism > Mitochondrial markers
Metabolism > Pathways and Processes > Mitochondrial Metabolism > Oxidative phosphorylation > Complex V
Metabolism > Types of disease > Cancer
Signal Transduction > Metabolism > Mitochondrial
Signal Transduction > Metabolism > Plasma Membrane > ATPases
Mitochondrial membrane ATP synthase (F(1)F(0) ATP synthase or Complex V) produces ATP from ADP in the presence of a proton gradient across the membrane which is generated by electron transport complexes of the respiratory chain. F-type ATPases consist of two structural domains, F(1) - containing the extramembraneous catalytic core, and F(0) - containing the membrane proton channel, linked together by a central stalk and a peripheral stalk.

产品应用
| 应用 | 已检合格种属 | 预测种属 | 推荐稀释比例 |
|---|---|---|---|
| WB | Human, Mouse, Rat | 1:1000-2000 | |
| IHC-P | Human, Mouse, Rat | 1:100-500 | |
| IHC-F | Human, Mouse, Rat | 1:100-500 | |
| IF | Human, Mouse, Rat | 1:100-500 | |
| Flow-Cyt | Human | Mouse, Rat | 1:100-200 |
| ICC/IF | Human, Mouse, Rat | 1:100-200 |
交叉反应
交叉反应: Human, Mouse, Rat
相关产品
暂无相关产品